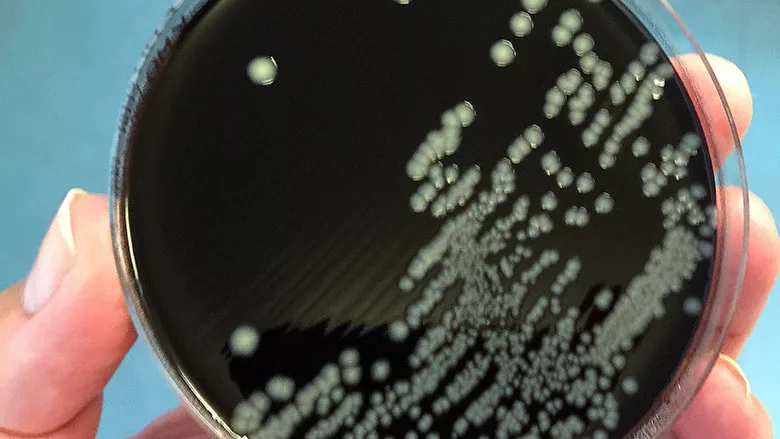

FDA Releases Data on AMR in Salmonella, Campylobacter
Credit: Scharvik/iStock / Getty Images Plus via Getty Images
The U.S. Food and Drug Administration (FDA) recently released the National Antimicrobial Resistance Monitoring System (NARMS) Integrated Summary for 2019. NARMS is a national public health system that tests bacteria from human and animal samples to monitor select pathogens’ antimicrobial resistance (AMR) to drugs used in human and veterinary medicine. NARMS is conducted in cooperation with the U.S. Centers for Disease Control and Prevention (CDC) and the U.S. Department of Agriculture’s Food Safety and Inspection Service (USDA FSIS). FDA, CDC, and FSIS are responsible for testing bacteria from raw retail meats, from human patients, and from animals at slaughter, respectively.
NARMS collects bacterial isolates from 15 distinct sources, but the summary prioritizes certain pathogens and antimicrobial drugs. Salmonella and Campylobacter are highlighted, along with drug classes that are considered most important to human medicine. FDA provides a comprehensive, interactive tool to review all the data from 2019 and previous years, called “NARMS Now: Integrated Data.”
NARMS data from 2019 shows no major change in the levels of AMR in Salmonella when compared to previous years. In samples collected from humans, 78 percent of Salmonella isolates were not resistant to any of the drugs tested under NARMS. When looking at specific serotypes, the following findings were observed:
- Salmonella Infantis remained notoriously resistant to critical drugs such as ceftriaxone
- Salmonella I 4,[5],12:i:- continued its increasing trend of resistance to multiple drugs, including the important antibiotics ceftriaxone and ciprofloxacin
- Regarding the drug azithromycin, only 1 percent of Salmonella showed decreased susceptibility, with Salmonella Newport making up the majority of the isolates
- None of the Salmonella isolates showed resistance to colistin, which is considered a drug of last resort for treating some multi-drug resistant pathogens.
Other notable findings from the NARMS 2019 report include Campylobacter’s continuously increasing resistance to fluoroquinolone; additional work is needed to understand what is causing this trend. Additionally, none of the tested Escherichia coli isolates showed resistance to colistin.
Looking for quick answers on food safety topics?
Try Ask FSM, our new smart AI search tool.
Ask FSM →








